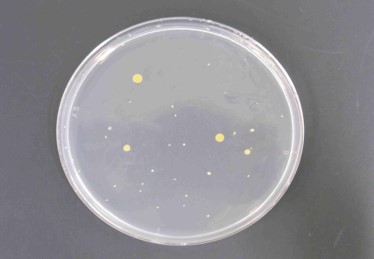

概要
不織布を含むすべての抗菌性繊維製品の抗菌活性を評価する試験です。
この試験規格は、布帛、詰めもの、糸、衣服素材、寝具、家具用繊維などを含む全ての繊維製品に適用され、抗菌加工方法、繊維製品の使用環境および表面特性から適切な方法を選択し、試験を行います。
菌液吸収法は、試験菌液を直接試験片上に接種する定量試験方法、
ハロー法は、ハローの有無によって評価する定性試験方法です。
試験方法
- 菌液吸収法
1)試験菌液を調整します。
2)試験片をバイアル瓶に入れ、滅菌します。
3)試験片に試験菌液を接種し、18時間~24時間培養します。

4)洗い出し液を加えて菌を洗い出します。

5)寒天培地と混和し培養します。


6)コロニー数を数え、生菌数を算出し、抗菌活性値を求めます。
抗菌活性値 A=(logCt-logC0)-(logTt-logT0)=F-G
A:抗菌活性値
F:対照試料の増殖値(F=logCt-logC0)
G:試験試料の増殖値(G=logTt-logT0)
locCt:18時間~24時間培養後の対照試料3検体の生菌数の算術平均の常用対数値の平均値
locC0:接種直後の対照試料3検体の生菌数の算術平均の常用対数値の平均値
locTt:18時間~24時間培養後の試験試料3検体の生菌数の算術平均の常用対数値の平均値
locT0:接種直後の試験試料3検体の生菌数の算術平均の常用対数値の平均値
試験結果サンプル
【評価基準】
- 菌液吸収法
JIS L 1902:2015
抗菌効果:抗菌活性値 ≧ 2.0
※(一社)繊維評価技術協議会「SEKマーク繊維製品認証基準」
抗菌防臭加工:抗菌活性値 ≧ 2.2
制菌加工(一般用途):抗菌活性値≧標準布の増殖値
制菌加工(特定用途):抗菌活性値>標準布の増殖値
試験方法
2.ハロー法
1) 試験菌液を調整し、寒天培地と混ぜて凝固させます。
2) 試験片を円形に採取し、滅菌します。
3) 1)の培地に2)の試験片を置いて密着させ、24時間~48時間培養します。
4)試験片の周囲にできたハローについて測定し、ハローの幅を計算します。
W=(T-D)/2
W:ハローの幅(mm)
T:試験片の長さとハローの幅との合計(mm)
D:試験片の長さ(mm)
試験結果サンプル
・ハロー法:ハローがあるもの
その他特記事項
一般社団法人繊維評価技術協議会では、JIS L 1902に基づく性能評価により、抗菌防臭加工と制菌加工のマーク認証が行われています。QTEC神戸試験センターは独立行政法人製品評価技術基盤機構よりJNLA登録試験事業者として登録されており、一般社団法人繊維評価技術協議会の指定試験機関として抗菌性能評価試験を実施しています。なお、上海総合試験センターの抗菌性試験の登録は取り下げております。
【加工の種類と試験対象菌種】
(一社)繊維評価技術協議会「SEKマーク繊維製品認証基準」による
●印は試験対象必須菌、〇印はオプション菌
抗菌防臭加工:繊維上の細菌の増殖を抑制し、防臭効果を示すことを目的とする加工
制菌加工:繊維上の細菌の増殖を抑制することを目的とする加工
試験片必要量
・菌液吸収法…1菌種あたり約5g
・ハロー法…条件により異なりますので、お問い合わせください。





